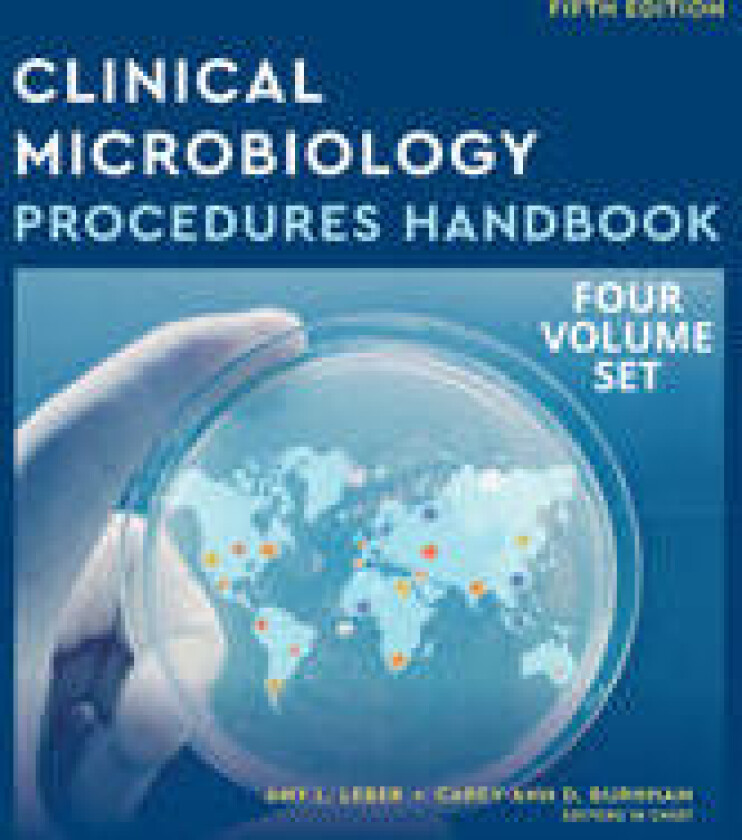
Bilde av Clinical Microbiology Procedures Handbook, Multi-Volume

JOHN WILEY & SONS INCApplications of Synthetic Resin Latices, Latices in Diverse Applications
Beste pris fra kr 5 887 og finnes i 1 butikk.
Populære alternativer
Se andre populære bøkermerker:
Prishistorikk
Prisvarsel
Meld deg opp til prisvarsel og få beskjed med en gang prisen synker.
kr
Strekkoder
GTIN
9780471954620